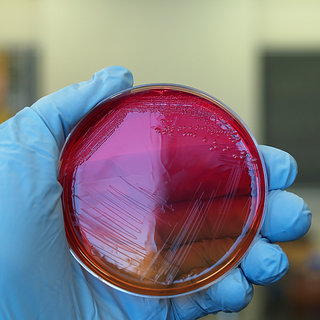

Clinical microbiology
臨床微生物學Instructor:
吳雪霞
Hsueh Hsia Wu
College of Medicine
Taipei Medical University
Course Structure: 2 hour per a week
Course Description
1. Introduction of the importance of clinical microbiology lab and how to establish it.
2. Introduction of the characteristics and the pathogenesis of each microorganisms.
1. 說明臨床微生物實驗室的重要性及如何建立。
2. 介紹臨床微生物相關各菌種的特性及其致病機制。
- 開課系所:醫學檢驗暨生物技術學系
- 開課年級: 3
- 學分:2